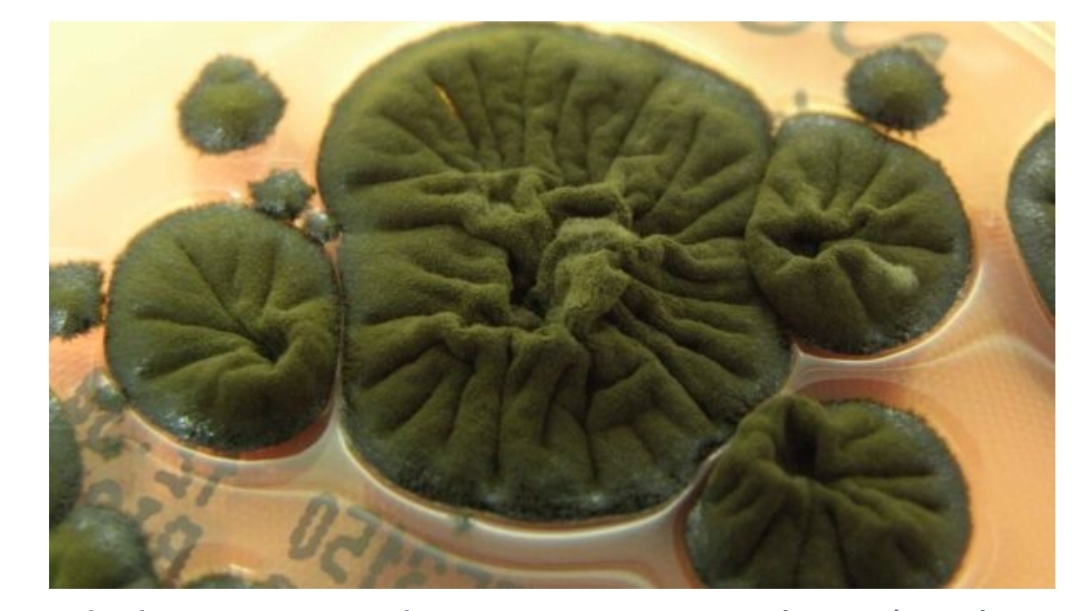
Ο μύκητας του Τσερνόμπιλ που “τρέφεται” με ακτινοβολία: Η ανακάλυψη που έχει αφήσει άφωνους τους επιστήμονες

ΟΙ ΤΡΑΠΕΖΟΫΠΑΛΛΗΛΟΙ ΔΙΕΚΔΙΚΟΥΝ ΤΗΝ ΠΛΗΡΗ ΔΙΑΣΦΑΛΙΣΗ ΤΩΝ ΘΕΣΕΩΝ ΕΡΓΑΣΙΑΣ ΚΑΙ ΤΗΝ ΥΠΟΓΡΑΦΗ ΝΕΩΝ ΕΠΙΧΕΙΡΗΣΙΑΚΩΝ ΣΣΕ
ΓΡΑΦΕΙ Ο Αθανάσιος Κώτσιος, Γενικός Σύμβουλος της ΟΤΟΕ και Επικεφαλής του Νομαρχιακού Παραρτήματος της ΟΤΟΕ στον νομό Λάρισας για την απεργία της Τρίτης 21 Ιουνίου στις τράπεζες Εθνική και Πειραιώς
Στην απεργία της Τρίτης 21 Ιουνίου 2022, οι εργαζόμενοι στην Εθνική Τράπεζα και την Τράπεζα Πειραιώς θα στείλουν ξεκάθαρο μήνυμα αντίστασης :
▪στη συρρίκνωση του Δικτύου των καταστημάτων.
▪στη βιομηχανία των αποσχίσεων και στην εξωτερίκευση εργασιών προς τρίτες εταιρείες.
▪στο κλίμα εργασιακής ανασφάλειας και συνεχούς απαξίωσης της προσφοράς των εργαζομένων στον τραπεζικό κλάδο.
Συμμετέχουμε όλοι και όλες στην πανελλαδική απεργία των εργαζομένων στις τράπεζες Εθνική και Πειραιώς την Τρίτη 21 Ιουνίου.
Στέλνουμε ισχυρό μήνυμα απέναντι στις Διοικήσεις των τραπεζών και στην προκλητική τους στάση όχι μόνο στο θέμα της υπογραφής επιχειρησιακών συμβάσεων, αλλά και σε όλο το πλαίσιο των εργασιακών μας σχέσεων, τις οποίες προσπαθούν να αποσαρθρώσουν.
Απαντούμε στην ανάλγητη στάση της Διοιηκήσεων στο θέμα της υπογραφής επιχειρησιακών συμβάσεων.
Διεκδικούμε αγωνιστικά καλύτερους όρους στις επιχειρησιακές μας συμβάσεις τόσο στο οικονομικό όσο και στο θεσμικό σκέλος.
Το κύμα της ακρίβειας και ο πληθωρισμός έχουν προκαλεσει σοβαρή μείωση στο εισόδημα των εργαζομένων στις τράπεζες.
Οι Τράπεζες παρουσιάζουν σημαντικά κέρδη. Οφείλουν να ενισχύσουν τους μισθούς και τα επιδόματα των εργαζομένων που τα παράγουν.
Διεκδικούμε την πλήρη διασφάλιση των θέσεων εργασίας και την υπογραφή νέων Επιχειρησιακών ΣΣΕ.
Συμμετέχουμε στην απεργία της Τρίτης 21 Ιουνίου. Στέλνουμε μήνυμα αντίδρασης κι αγώνα.
Προσοχή! Επιτρέπεται η αναδημοσίευση των πληροφοριών του παραπάνω άρθρου ή μέρους αυτών μόνο αν αναφέρεται ως πηγή το https://paidis.com/ και υπάρχει ενεργός σύνδεσμος.